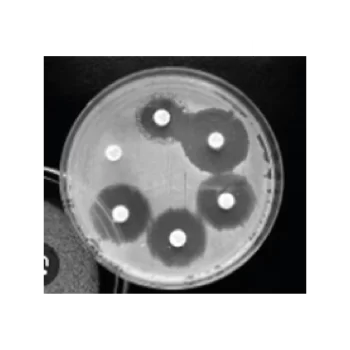

Showing 199–207 of 337 results
Oxoid™ Cefoxitin Antimicrobial Susceptibility discs / Discos de susceptibilidad antimicrobiana Oxoid™ cefoxitina
S/ 0.00
[SKU: CT0119B]
Determine manualmente la susceptibilidad a los antibióticos de los microorganismos utilizando métodos de prueba de susceptibilidad a los antimicrobianos (AST) junto con discos de susceptibilidad a los antimicrobianos Thermo Scientific™ Oxoid™ Cefoxitin, fiables y fáciles de usar.
Oxoid™ Cefpodoxime Antimicrobial Susceptibility discs / Discos de susceptibilidad antimicrobiana a cefpodoxima Oxoid™
S/ 0.00
[SKU: CT1612B]
Determine manualmente la susceptibilidad a los antibióticos de los microorganismos mediante métodos de prueba de susceptibilidad a los antimicrobianos (AST) junto con discos de susceptibilidad a los antimicrobianos Thermo Scientific™ Oxoid™ de cefpodoxima, fiables y fáciles de usar.
Oxoid™ Ceftazidime Antimicrobial Susceptibility discs / Discos de susceptibilidad antimicrobiana a ceftazidima Oxoid™
S/ 0.00
[SKU: CT0412B]
Determine manualmente la susceptibilidad a los antibióticos de los microorganismos mediante métodos de prueba de susceptibilidad a los antimicrobianos (AST) junto con discos de susceptibilidad a los antimicrobianos de ceftazidima Thermo Scientific™ Oxoid™ fiables y fáciles de usar.
Oxoid™ ceftizoxime antibiogram discs, 30 µg / Discos para antibiograma con ceftizoxima Oxoid™, 30 µg
S/ 0.00
[SKU: CT0477B]
Evalúe la sensibilidad de los microorganismos utilizando métodos AST manuales, con la ayuda de una amplia selección de discos para antibiogramas.
Oxoid™ Ceftriaxone Antimicrobial Susceptibility discs / Discos de susceptibilidad antimicrobiana a ceftriaxona Oxoid™
S/ 0.00
[SKU: CT0417B]
Determine manualmente la susceptibilidad a los antibióticos de los microorganismos utilizando métodos de prueba de susceptibilidad a los antimicrobianos (AST) junto con discos de susceptibilidad a los antimicrobianos de ceftriaxona Thermo Scientific™ Oxoid™ fiables y fáciles de usar.
Oxoid™ Cefuroxime Sodium Antimicrobial Susceptibility discs / Discos de susceptibilidad antimicrobiana a cefuroxima sódica Oxoid™
S/ 0.00
[SKU: CT0127B]
Determine manualmente la susceptibilidad a los antibióticos de los microorganismos mediante métodos de prueba de susceptibilidad a los antimicrobianos (AST) junto con discos de susceptibilidad a los antimicrobianos de cefuroxima sódica Thermo Scientific™ Oxoid™, fiables y fáciles de usar.
Oxoid™ Cephalexin Antimicrobial Susceptibility Discs, 30 µg / Discos de sensibilidad antimicrobiana con cefalexina Oxoid™, 30 µg
S/ 0.00
[SKU: CT0007B]
Determine la sensibilidad de los microorganismos usando métodos AST manuales y una amplia gama de discos para antibiogramas manuales de gran calidad y fácil uso.
Oxoid™ Cephazolin Antimicrobial Susceptibility discs / Discos de susceptibilidad antimicrobiana a cefazolina Oxoid™
S/ 0.00
[SKU: CT0011B]
Determine manualmente la susceptibilidad a los antibióticos de los microorganismos mediante métodos de prueba de susceptibilidad a los antimicrobianos (AST) junto con discos de susceptibilidad a los antimicrobianos de cefazolina Thermo Scientific™ Oxoid™ fiables y fáciles de usar.
Oxoid™ Chloramphenicol Antibiogram Discs / Discos para antibiograma con cloranfenicol Oxoid™
S/ 0.00
[SKU: CT0014B]
Evalúe la sensibilidad de los microorganismos utilizando métodos AST manuales, con la ayuda de una amplia selección de discos para antibiogramas.